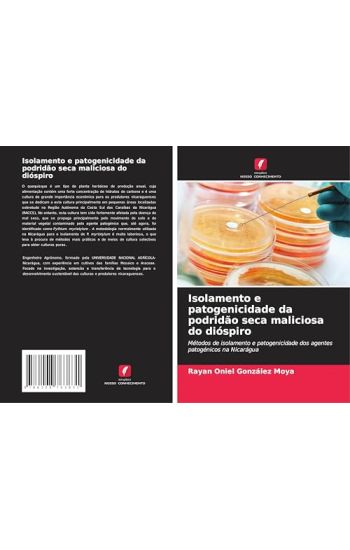
Isolamento e patogenicidade da podridão seca maliciosa do dióspiro

Soul Work 101 Identity: A Practical Workbook Guide to the expression of your "True Self"
Moya E. Brathwaite · ISBN 9781688399822
Julkaistu 2019 Kieli englanti nidottu
469 tulosta hakusanalla Moya E. Brathwaite.

Moya E. Brathwaite · ISBN 9781688399822
Julkaistu 2019 Kieli englanti nidottu

Francisco Moya · ISBN 9781072558576
Julkaistu 2019 Kieli portugali nidottu
Qual o objetivo principal deste trabalho ?Dotar voc de conhecimentos adequados para aprender e treinar sua mente a se energizar, elevando sua for a f sica, mental e espiritual,...

Rayan Oniel González Moya · ISBN 9786208763817
Julkaistu 2025 Kieli italia nidottu
Rayan Oniel González Moya · ISBN 9786208763831
Julkaistu 2025 Kieli portugali pokkari
O quequisque um tipo de planta herb cea de produ o anual, cuja alimenta o cont m uma forte concentra o de hidratos de carbono e uma cultura de grande import ncia econ mica para...

Héctor Moya · ISBN 9786206396208
Julkaistu 2023 Kieli portugali pokkari

Héctor Moya · ISBN 9786206396222
Julkaistu 2023 Kieli italia pokkari

María Florencia Moya · ISBN 9786204762548
Julkaistu 2022 Kieli portugali nidottu

Luis Moya · ISBN 9786206508632
Julkaistu 2023 Kieli portugali nidottu

María Florencia Moya · ISBN 9783841754240
Julkaistu 2022 Kieli espanja nidottu

Jeannegda Catherine Valverde Farías; Egda Isbelia Farias Moya · ISBN 9786208203467
Julkaistu 2024 Kieli portugali pokkari
Atualmente, apesar dos progressos cient ficos e de a medicina ser mais complexa do que h v rios s culos, o seu exerc cio n o est isento de erros, por vezes fatais. A neglig ncia...

Jos? Moya Ruiz · ISBN 9783845480060
Julkaistu 2012 Kieli espanja pokkari

Hidalgo Moya · ISBN 9789354308161
Julkaistu 2020 Kieli englanti pokkari
This book has been considered by academicians and scholars of great significance and value to literature. This forms a part of the knowledge base for future generations. So that...
"Moya" is a novel that focuses on spiritual warfare and mythology in the modern South Africa / African cultural landscape. This book is based on letters written in the form of s...

Pokazan'ev Aleksandr · ISBN 9783847380429
Julkaistu 2012 Kieli venäjä pokkari

Ali Mitgutsch · ISBN 9789661051019
Julkaistu 2018 Kieli ukraina sidottu